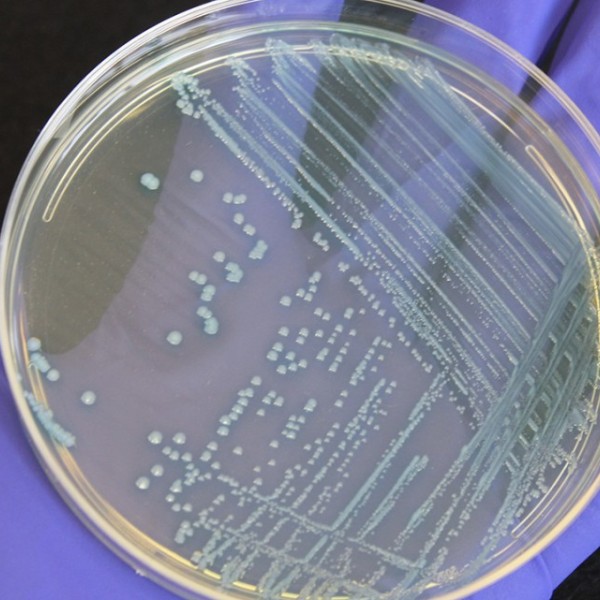
Listeria on a petri dish held by a purple gloved hand
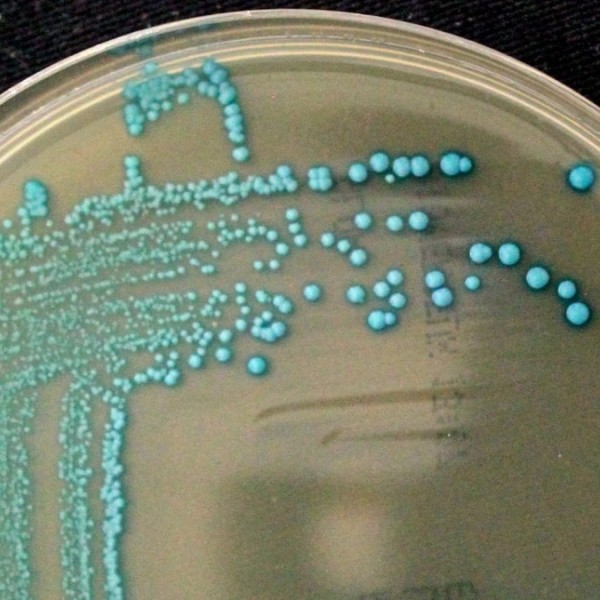
Blue-looking listeria cossartiae on a petri dish

Search for News & Stories
News
Cornell-led research argues that food safety regulations should set evidence-based targets for food that is sufficiently safe rather than aiming for zero risk, which is neither achievable nor desirable.
News
Americans eat more romaine than any other lettuce. But it has been plagued by recurrent foodborne-illness outbreaks.
News
Researchers have created a computer model that can help produce farms and food processing facilities control COVID-19 outbreaks, keeping workers safe and the food chain secure.
News
After examining pasteurized single-serving milk cartons, Cornell food scientists found bacterial counts two weeks after processing were higher than in larger containers from the same facilities.
News
Cornell food scientists show that a standard quality test used for raw, organic milk is insufficient for distinguishing between specific groups of bacteria -- suggesting that criteria needs updating.
News
A new filtration process that aims to extend milk’s shelf life may result in a pasteurization-resistant microbacterium passing into milk if equipment isn’t properly cleaned early, Cornell scientists say.
News
News
News
News
News
News
News
News
News
News
News
News
The remote videoconference – the first of three sessions – can be accessed here. Food science panelists will be Sam Alcaine, assistant professor; Olga Padilla-Zakour, professor; and Martin Wiedmann, the Gellert Family Professor in Food Safety...
News
News

We openly share valuable knowledge. Often through email.
Sign up for more insights, discoveries and solutions.